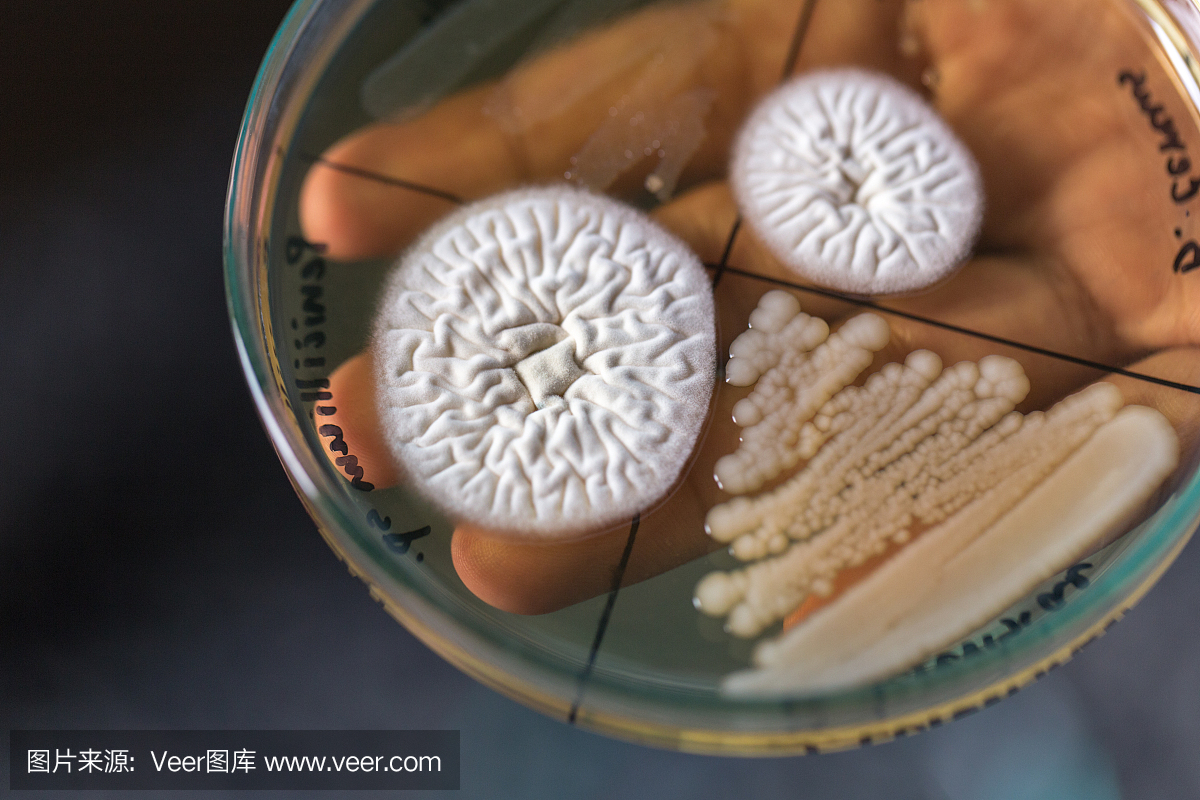
实验室教育实验室培养皿中细菌和真菌的研究。

卡通细菌真菌病毒png海报素材图片下载png素材-装饰图案-我图网
780x585 - 174KB - JPEG
细菌真菌
658x411 - 134KB - JPEG

蓝藻是细菌、真菌、动物还是植物?-真菌 细菌 是动物还是植物啊? _感人网
802x581 - 67KB - JPEG

在白色隔离的琼脂平板上的细菌和真菌菌落
1200x1173 - 577KB - JPEG

卡通细菌真菌病毒病菌图片素材图片下载png素材-其他-我图网
780x585 - 164KB - JPEG

酵母菌是真菌还是细菌和酵母的区别 酵母菌的作用与功效及危害
600x387 - 72KB - JPEG

【细菌和真菌的区别】【图】细菌和真菌的区别有什么 细菌和真菌两大用处介绍_伊秀健康|yxlady.com
600x380 - 64KB - JPEG

厨房抹布(含有细菌、真菌菌丝和酵母菌)_酵母菌是真菌吗-摄影学习网
450x336 - 207KB - JPEG

《细菌和真菌在自然界中的作用》教学设计
476x327 - 140KB - PNG

谁能给我找几张病毒或细菌或真菌的图片
500x333 - 25KB - JPEG

卡通细菌病毒真菌海报PNG素材(图片编号:16039323)_其他_我图网
780x585 - 169KB - JPEG

八年级生物:初二生物细菌、真菌和病毒复习精品中学课件.ppt
1161x864 - 1043KB - PNG
实验室教育实验室培养皿中细菌和真菌的研究。
1200x800 - 789KB - JPEG

卡通医院医疗细菌真菌病毒病菌螨虫PNG
1024x768 - 179KB - JPEG

人教生物八上5.5.1 细菌和真菌在自然界中的作用 课件(民众中学 生物科组)-中国教育出版网
599x445 - 618KB - PNG
细菌和真菌的名称中均有一个“菌”字,同属微生物,但两者在生物类型、结构、大小、增殖方式和名称上却有着诸多不同: a.生物类型的不同, 细菌没有核膜包围形成的细胞核,属于原核生物; 真菌有核膜包围形成的细胞核,属于真核生物。 细菌全部是由单个细胞构成,为单细胞型生物; 真菌既有由单个细胞构成的单细胞型生物(如酵母菌),也有由多个细胞构成的多细胞型生物(如食用菌、霉菌等)。 b.细胞结构不同, 细菌和真菌都具有细胞结构,属于细胞型生物,在它们的细胞结构中都具有细胞壁、细胞膜、细胞质,
照明等其它细菌在有氧条件下分解有机物能产生二氧化碳和水 3、培养细菌和真菌的一般方法 1配制培养基琼脂+牛肉汁为细菌、真菌提供营养物质。 2高温灭菌将配制好的培
细菌、真菌和病毒有什么区别? bdkj_2010_wl|2018-06-28 |举报 专业文档 专业文档是百度文库认证用户/机构上传的专业性文档,文库VIP用户或购买专业文档下载特权礼包的其
爱华植保经过10多年的潜心研究,发现速渡对庄稼疑难病害防治效果特别显著,创造了一个新农药对作物细菌、真菌、病毒都能防治的奇迹。为众多的
大家经常会听说细菌感染、真菌感染以及病毒感染等说法,不管是细菌、真菌还是病毒,个体都是非常小的,至少人的肉眼是看不到的,真菌和细菌感染
细菌和真菌的名称中均有一个“菌”字,同属微生物,但两者在生物类型、结构、大小、增殖方式和名称上却有着诸多不同: A.生物类型的不同,细菌没有核膜包围形成的细胞核,属
简介:真菌,是一种真核生物。最常见的真菌是各类蕈类,另外真菌也包括霉菌和酵母。现在已经发现了七万多种真菌
如果非要笼统概括一下,个人认为病毒≥细菌 真菌。病毒的繁殖能力极强,且极易变异;细菌主要通过内毒素(菌体本身)和外毒素(分泌)致病,繁殖力和变异率虽不及病毒,但分布比病
一、理论学习班须知 1.学员资质及要求 (1)感染科专科医师优先; (2)尚接受在医院内承担感染病诊治的其他专科临床医师。备注:已在院内从事以细菌真菌感染为主的感染病区或